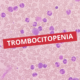

Interações medicamentosas
As interações medicamentosas acontecem quando dois ou mais fármacos administrados simultaneamente alteram a ação, a eficácia ou a toxicidade de um deles. Compreender esses fenômenos é essencial para reduzir riscos, otimizar terapias e garantir segurança ao paciente.
No contexto clínico, a avaliação das interações medicamentosas envolve conhecimento da farmacocinética, farmacodinâmica e do perfil individual de cada paciente, incluindo idade, comorbidades e uso de múltiplos medicamentos.
Tipos de interações medicamentosas
As interações podem ser classificadas de acordo com seu mecanismo:
1. Farmacocinéticas
Ocorrem quando um fármaco altera a absorção, distribuição, metabolismo ou excreção de outro, modificando sua concentração plasmática.
Exemplos:
- Inibição ou indução enzimática do citocromo P450, que pode aumentar ou reduzir a eficácia de fármacos metabolizados por essas enzimas.
- Alterações do pH gástrico que interferem na absorção de determinados medicamentos.
- Competição renal para excreção, alterando a eliminação de fármacos ativos.
2. Farmacodinâmicas
Ocorrem quando dois fármacos atuam sobre o mesmo receptor ou via fisiológica, potencializando ou antagonizando efeitos.
Exemplos:
- Uso concomitante de anticoagulantes orais e anti-inflamatórios, que aumenta o risco de sangramento.
- Combinação de sedativos ou benzodiazepínicos com álcool, que potencializa depressão do sistema nervoso central.
- Fármacos antagonistas nos receptores β-adrenérgicos, que podem reduzir a eficácia terapêutica de um ou outro medicamento.
3. Mistos ou complexos
Algumas interações envolvem alterações farmacocinéticas e farmacodinâmicas ao mesmo tempo, exigindo monitoramento mais rigoroso e avaliação clínica detalhada.
Fatores que influenciam interações
Diversos fatores aumentam o risco de interações medicamentosas:
- Polifarmácia: o uso de múltiplos medicamentos eleva o risco de forma exponencial.
- Idade e função orgânica: crianças, idosos e pacientes com insuficiência hepática ou renal têm maior vulnerabilidade.
- Genética: polimorfismos enzimáticos podem alterar metabolismo de fármacos.
- Comorbidades e hábitos de vida: dieta, consumo de álcool e tabagismo podem modificar a ação de medicamentos.
Consequências clínicas
As interações medicamentosas podem resultar em efeitos variados, desde discretos até potencialmente graves:
- Potenciação de efeitos terapêuticos, aumentando o risco de toxicidade.
- Redução da eficácia, gerando falha terapêutica.
- Eventos adversos inesperados, que podem aumentar hospitalizações.
- Alterações laboratoriais, interferindo em exames clínicos e diagnósticos.
Exemplos clínicos relevantes
Algumas interações com repercussão significativa incluem:
- Varfarina e AINEs: risco aumentado de sangramento devido à ação aditiva sobre a coagulação.
- Omeprazol e clopidogrel: redução da eficácia antitrombótica do clopidogrel por efeito no metabolismo hepático.
- Digoxina e quinidina: elevação da concentração plasmática da digoxina, aumentando o risco de toxicidade cardíaca.
- Benzodiazepínicos e álcool: potencialização da depressão do sistema nervoso central, podendo causar sedação excessiva e comprometimento respiratório.
Prevenção e manejo
A prevenção das interações medicamentosas baseia-se em três pilares:
- Anamnese completa: levantamento detalhado de todos os medicamentos, suplementos e fitoterápicos em uso.
- Monitoramento clínico e laboratorial: ajuste de doses e acompanhamento de sinais de toxicidade.
- Uso de ferramentas digitais e referências confiáveis: bancos de dados de interações, guidelines e softwares de prescrição segura.
A educação do paciente sobre a importância de relatar todos os fármacos consumidos é essencial para reduzir riscos.
As interações medicamentosas representam um desafio constante na prática clínica, exigindo conhecimento atualizado e abordagem multidisciplinar. A identificação precoce, o monitoramento contínuo e a análise crítica das combinações terapêuticas são fundamentais para garantir segurança e eficácia no tratamento.
Potencialize seus estudos de farmacologia e de toda a graduação com o Cursau Hub, a plataforma inteligente que melhora seu desempenho em provas em apenas 7 dias.